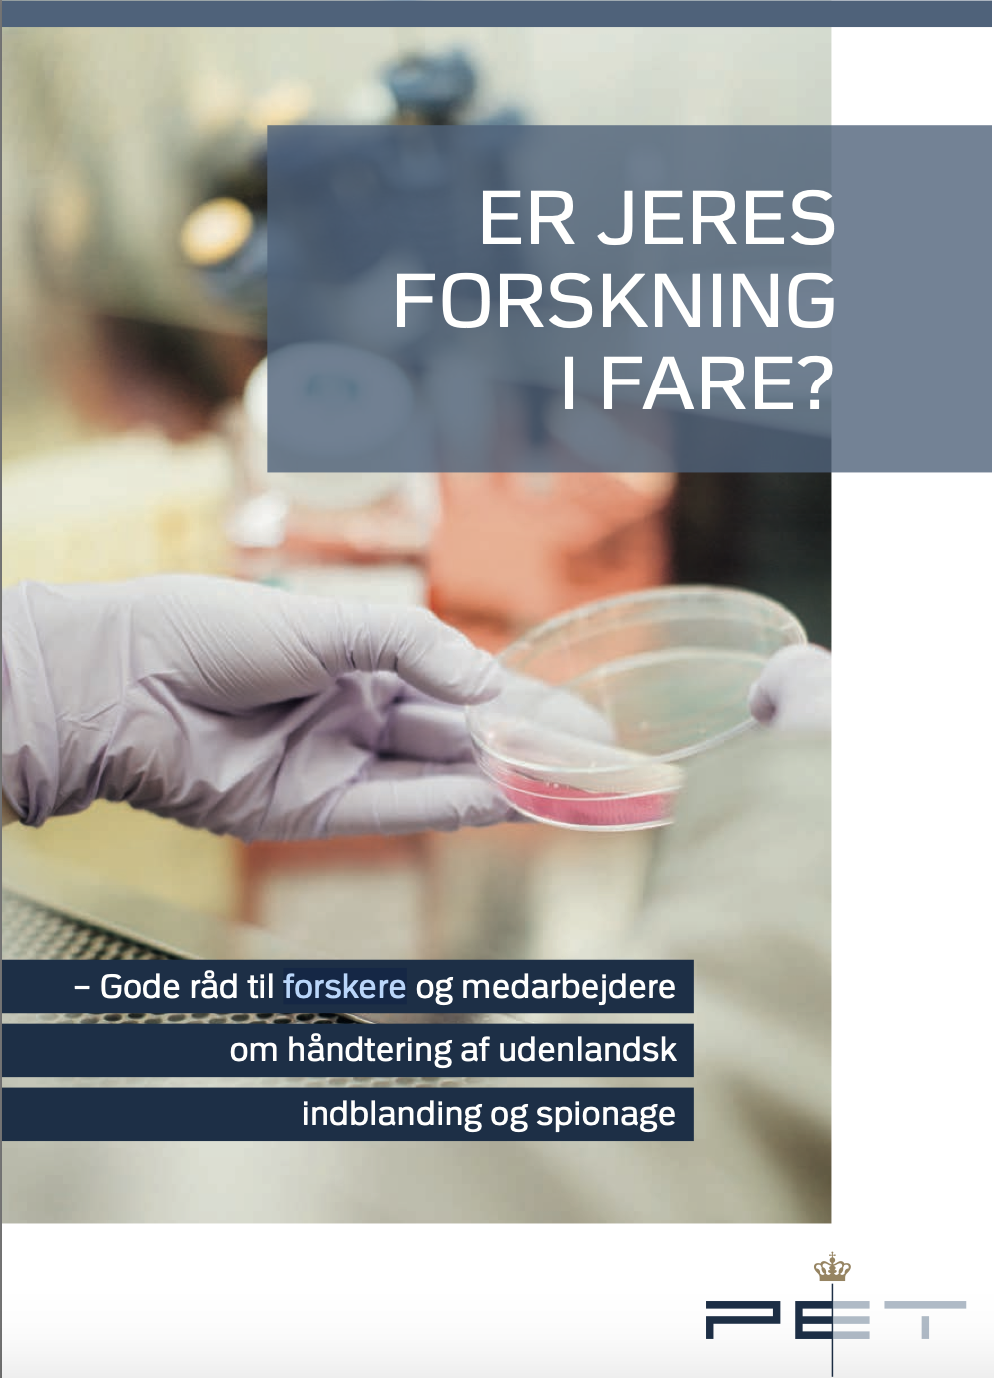

Er jeres forskning i fare?
Gode råd til forskere og medarbejdere om håndtering af udenlandsk indblanding og spionage fra Uddannelses- og Forskningsministeriet og PET.
Vi skal være bedre rustet
Danmark har et højt niveau inden for teknologi, innovation og forskning, og danske forskningsinstitutioner indga?r aktivt i internationalt samarbejde pa? disse omra?der. Det er med til at udvikle og bidrage til Danmarks fremtrædende position bl.a. inden for en række forskningsomra?der. Imidlertid er dansk forskning i skarp international konkurrence, og forskningen kan havne i de forkerte hænder.
Hovedparten af det internationale forskningssamarbejde er til Danmarks fordel. Men der er desværre ogsa? eksempler pa?, at fremmede stater uretmæssigt anskaffer sig viden, teknologi og produkter, som Danmark skal leve af pa? sigt, eller som kan have en negativ indflydelse sikkerhedspolitisk. Derfor har PET, i samarbejde med Uddannelses- og Forskningsministeriet, udarbejdet en række anbefalinger til jer, der arbejder pa? forskningsinstitutioner, for at forebygge og ha?ndtere udenlandsk indblanding og spionage.